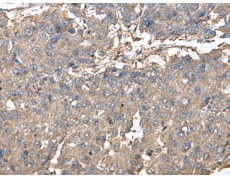
一抗

|
Background: |
The protein encoded by this gene may play a role in intracellular vesicle trafficking. It interacts with Syntaxin 13 which mediates intracellular membrane fusion. Mutations in this gene cause symptoms associated with Hermansky-Pudlak syndrome-9. Alternative splicing results in multiple transcript variants. A pseudogene related to this gene is located on the X chromosome. |
|
Applications: |
ELISA, WB, IHC |
|
Name of antibody: |
BLOC1S6 |
|
Immunogen: |
Fusion protein of human BLOC1S6 |
|
Full name: |
biogenesis of lysosomal organelles complex 1 subunit 6 |
|
Synonyms: |
PA; HPS9; PLDN; BLOS6; PALLID |
|
SwissProt: |
Q9UL45 |
|
ELISA Recommended dilution: |
5000-10000 |
|
IHC positive control: |
Human liver cancer |
|
IHC Recommend dilution: |
100-300 |
|
WB Predicted band size: |
20 kDa |
|
WB Positive control: |
231, Hela, Jurkat, 293T, K562 and HepG2 cell lysates |
|
WB Recommended dilution: |
1000-5000 |


 購物車
購物車 幫助
幫助
 021-54845833/15800441009
021-54845833/15800441009